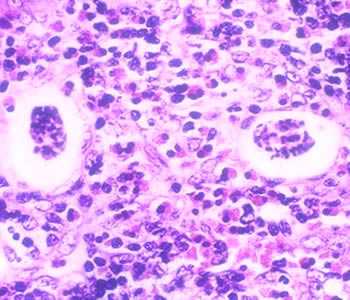
Figure B

Angiostrongyliasis
[Angiostrongylus cantonensis] [Angiostrongylus costaricensis]
Causal Agents
The nematode (roundworm) Angiostrongylus cantonensis, the rat lungworm, is the most common cause of human eosinophilic meningitis. In addition, Angiostrongylus (Parastrongylus) costaricensis is the causal agent of abdominal, or intestinal, angiostrongyliasis.
Life Cycle

Adult worms of A. cantonensis live in the pulmonary arteries of rats. The females lay eggs that hatch, yielding first-stage larvae, in the terminal branches of the pulmonary arteries. The first-stage larvae migrate to the pharynx, are swallowed, and passed in the feces. They penetrate, or are ingested by, an intermediate host (snail or slug). After two molts, third-stage larvae are produced, which are infective to mammalian hosts. When the mollusk is ingested by the definitive host, the third-stage larvae migrate to the brain where they develop into young adults. The young adults return to the venous system and then the pulmonary arteries where they become sexually mature. Of note, various animals act as paratenic (transport) hosts: after ingesting the infected snails, they carry the third-stage larvae which can resume their development when the paratenic host is ingested by a definitive host. Humans can acquire the infection by eating raw or undercooked snails or slugs infected with the parasite; they may also acquire the infection by eating raw produce that contains a small snail or slug, or part of one. There is some question whether or not larvae can exit the infected mollusks in slime (which may be infective to humans if ingested, for example, on produce). The disease can also be acquired by ingestion of contaminated or infected paratenic animals (crabs, freshwater shrimps). In humans, juvenile worms migrate to the brain, or rarely in the lungs, where the worms ultimately die. The life cycle of Angiostrongylus (Parastrongylus) costaricensis is similar, except that the adult worms reside in the arterioles of the ileocecal area of the definitive host. In humans, A. costaricensis often reaches sexual maturity and release eggs into the intestinal tissues. The eggs and larvae degenerate and cause intense local inflammatory reactions and do not appear to be shed in the stool.
Geographic Distribution
Most cases of eosinophilic meningitis have been reported from Southeast Asia and the Pacific Basin, although the infection is spreading to many other areas of the world, including Africa and the Caribbean. Abdominal angiostrongyliasis has been reported from Costa Rica, and occurs most commonly in young children.
Clinical Presentation
Clinical symptoms of eosinophilic meningitis are caused by the presence of larvae in the brain and by local host reactions. Symptoms include severe headaches, nausea, vomiting, neck stiffness, seizures, and neurologic abnormalities. Occasionally, ocular invasion occurs. Eosinophilia is present in most of cases. Most patients recover fully. Abdominal angiostrongyliasis mimics appendicitis, with eosinophilia.
Angiostrongylus costaricensis eggs and larvae in tissue stained with hematoxylin and eosin (H&E).
In humans, Angiostrongylus eggs and larvae are not normally excreted but remain sequestered in tissues. A. costaricensis infections are predominantly abdominal; both eggs and larvae (occasionally adult worms) can be identified in biopsy or surgical specimens of intestinal tissue where the eggs and larvae are engulfed in giant cells and/or granulomas. A. cantonensis infections are predominantly cerebral, being one of the most common causes of eosinophilic meningitis, although developing but immature adult worms can on occasion migrate to the lungs. No A. cantonensis eggs or larvae have been recognized in human tissues.
The larvae of A. costaricensis need to be distinguished from larvae of Strongyloides stercoralis. A. costaricensis first stage (L1) larvae tend to be slightly smaller in diameter than Strongyloides and have a single lateral ala, whereas Strongyloides third stage (L3) larvae have minute double lateral alae. The alae can be difficult to discern in most histologic sections. However, the presence of granulomas containing thin shelled eggs and/or larvae generally serve to distinguish A. costaricensis infections from Strongyloides infections.

Figure A: Angiostrongylus costaricensis eggs in intestinal tissue stained with hematoxylin and eosin (H&E).
Figure B: Thin-shelled A. costaricensis eggs in intestinal tissue stained with H&E, a feature consistent with the presence of mature female worms.

Figure C: A. costaricensisfirst stage (L1) larva in intestinal tissue stained with H&E
Angiostrongylus costaricensis adult female in tissue sections stained with H&E.

Figure A: Angiostrongylus costaricensis female worm in appendix tissue sections stained with hematoxylin and eosin (H&E). Image courtesy of Regions Hospital, St. Paul, MN.

Figure B: Higher magnification of the specimen in Figure A. Notice the thick, multinucleate intestine (IN) and eggs (EG) within the uterus (UT).

Figure C: Another image from the specimen seen in Figure A.

Figure D: Higher magnification of the specimen in Figure C. Shown here are the thick, multinucleate intestine (IN), reproductive tubes (RT), and lateral chords (LC).
Angiostrongylus sp. male worms.

Figure A: Angiostrongylus sp. male worm, approximately 4.25 mm in length, recovered from vitreous humor of a human patient. The worm is most likely A. cantonensis based on the patient's geographic location.

Figure B: Angiostrongylus worm. Note the very long spicules (black arrows), one of the indications that this is a male worm.

Figure C: Higher magnification of the worm in Figure B.

Figure D: Angiostrongylus adult worm recovered from vitreous humor of a human patient. The bursa is one indication that this is a male worm. The worm is most likely A. cantonensis based on the patient's geographic location.

Figure E: Same specimen as in Figure D but in a different focal plane.
A. cantonensis larvae recovered from slugs.

Figure A: Angiostrongylus cantonensis third stage (L3), infective larva recovered from a slug. Image captured under differential interference contrast (DIC) microscopy.

Figure B: A. cantonensis (L3), infective larvae recovered from a slug. Image captured under DIC microscopy.

Figure C: Higher magnification of Image B. Note the terminal projection on the tip of the tail which is characteristic of A. cantonensis.
A. cantonensis larvae recovered from slugs.

Figure A: Angiostrongylus cantonensis third stage (L3), infective larva, in a wet mount, recovered from a slug. Note the terminal projection on the tip of the tail which is characteristic of A. cantonensis.

Figure B: A. cantonensis L3, infective larvae, in wet mounts, recovered from slugs.

Figure C: A. cantonensis L3, infective larvae, in wet mounts, recovered from slugs.
Laboratory Diagnosis
Morphologic Diagnosis
In eosinophilic meningitis with A. cantonensis, the cerebrospinal fluid (CSF) is abnormal (elevated pressure, proteins, and leukocytes; eosinophilia). On rare occasions, larvae have been found in the CSF. In abdominal angiostrongyliasis with A. costaricensis, eggs and larvae can be identified in biopsy specimens.
Molecular Diagnosis
The CDC offers a real-time PCR assay for the specific detection of A. cantonensis in human CSF specimens. The CSF should be kept cold and shipped to CDC on ice pack as soon as possible; alternatively it can be kept frozen until shipment is arranged. Shipment on dry ice is optional. Recommended volume of CSF is at least 2 ml. Volumes less than 1 ml may lead to reduced test sensitivity.
No specific molecular tests are available for A. costaricensis. A conventional PCR followed by DNA sequencing can be performed for A. costaricensis on a case-by case basis. Acceptable specimen type is tissue biopsies.
References
Qvarnstrom Y, da Silva AQA, Teem JL, Hollingsworth R, Bishop H, Graeff-Teixeira C, and da Silva AJ: Improved Molecular Detection of Angiostrongylus cantonensis in Mollusks and Other Environmental Samples with a Species-Specific Internal Transcribed Spacer 1-Based TaqMan Assay. Appl. Envir. Microbiol.; 2010; 76: 5287 - 5289.
Qvarnstrom Y, Sullivan JJ, Bishop HS, Hollingsworth R, da Silva AJ: PCR-based detection of Angiostrongylus cantonensis in tissue and mucus secretions from molluscan hosts. Appl. Environ. Microbiol.; 2007; 73:1415-1419.
Eamsobhanaa P, Limb PE, Solano G, Zhange H, Ganf X, Yongc HS: Molecular differentiation of Angiostrongylus taxa (Nematoda: Angiostrongylidae) by cytochrome c oxidase subunit I (COI) gene sequences. Acta Tropica; 2010; 116: 152–156.
Treatment Information
Angiostrongylus cantonensis
Treatment is usually supportive with the use of analgesics for pain and corticosteroids to limit the inflammatory reaction. Careful removal of CSF at frequent intervals can help to relieve headache in patients with elevated intracranial pressure. No anti-helminthic drugs have been proven to be effective in treatment, and there is concern that anti-helminthics could exacerbate neurological symptoms due to a systemic response to dying worms. The effectiveness of any regimen may vary by endemic region. One randomized, placebo-control study of a 2-week course of prednisolone (60 mg per day in 3 divided doses) found that the corticosteroids reduced the median length of headache from 13 days to 5 days and reduced the need for repeat lumbar puncture. Additionally 9.1% of treatment patients compared to 45.5% of controls still had headache at 2 weeks.
In two small cases series (41 and 26 adults, respectively) adult patients were given prednisolone 60 mg/day and an anti-helminthic (mebendazole 10 mg/kg/day or albendazole 15mg/kg/day two weeks, respectively), resulting in resolution of headache in a median of 3 days in the mebendazole case-series and 4 days in the albendazole case-series without serious side effects. As there was no control group, it is difficult to determine if the anthelminthic provided additional benefit. Comparing the results from the placebo-control trial to the 2 case-series, 9.1% of prednisolone monotherapy patients, 9.8% of prednisolone-mebendazole patients, and 11.5% of prednisolone-albendazole patients still had headache after 2 weeks. One small trial that directly compared prednisolone monotherapy to prednisolone-albendazole combined therapy found no benefit of adding albendazole to the regimen.
Additional symptomatic treatment may also be required for nausea, vomiting, and in some cases chronic pain due to nerve damage and muscle atrophy.
Angiostrongylus costaricensis
There is no proven treatment for illness caused by A. costaricensis and there is some concern that treatment with anthelminthics could result in worsening of the disease. Acute episodes may resolve spontaneously or require surgical treatment for intestinal inflammation.
Mebendazole
Mebendazole is available in the United States only through compounding pharmacies.
Note on Treatment in Pregnancy
Albendazole
Oral albendazole is available for human use in the United States.
Note on Treatment in Pregnancy
DPDx is an education resource designed for health professionals and laboratory scientists. For an overview including prevention and control visit www.cdc.gov/parasites/.
- Page last reviewed: October 17, 2016
- Page last updated: October 17, 2016
- Content source:
- Global Health – Division of Parasitic Diseases and Malaria
- Notice: Linking to a non-federal site does not constitute an endorsement by HHS, CDC or any of its employees of the sponsors or the information and products presented on the site.
- Maintained By:


 ShareCompartir
ShareCompartir